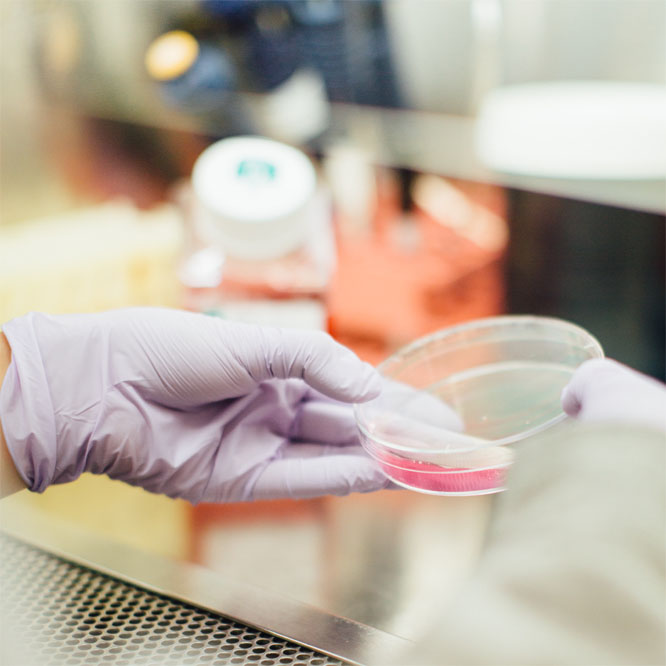
EPA Approved

Functional Disinfectants
Functional Disinfectants
Pandemic Solutions uses EPA-registered products to disinfect large areas against COVID-19 and other infectious diseases.
While surface disinfectant products on List N have not been tested specifically against SARS-CoV-2, the cause of COVID-19, EPA expects them to kill the virus because they:
- Demonstrate efficacy (e.g. effectiveness) against a harder-to-kill virus; or
- Demonstrate efficacy against another type of human coronavirus similar to SARS-CoV-2.
All surface disinfectants on List N can be used to kill viruses on surfaces such as counters and doorknobs.
Because SARS-CoV-2 is a new virus, this pathogen is not readily available for use in commercial laboratory testing to see if a certain disinfectant product is effective at killing the virus.
